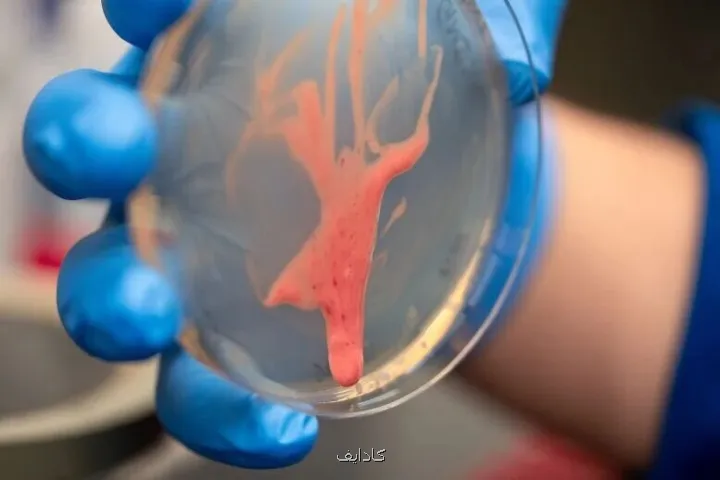
کشف راز یک قاتل نامرئی

کشف راز یک قاتل نامرئی
کادایف: دانشمندان دریافتند که یک باکتری مخرب با ترشح ماده ای لجن مانند و فوق العاده روان، سیستم آوندی گیاهان را می بندد و در عرض چند روز آنها را از بین می برد. این کشف می تواند راه را برای مبارزه مؤثرتر با این آفت خطرناک هموار کند.
به گزارش کادایف به نقل از خبر آنلاین، به نقل از ایرنا، یک بیماری گیاهی که می تواند محصولات کشاورزی را تنها در عرض چند روز نابود کند، به طرز شگفت آوری به یک سازوکار ساده متکی است: ماده ای چسبناک و روان که بیشتر شبیه لجن یا ژله رفتار می کند تا یک ماده تحقیقات جدید نشان میدهد که این ماده غیرمعمول به باکتری های رالستونیا (Ralstonia) کمک می نماید با کارآیی ویرانگری در گیاهان حرکت کنند و سبب پژمردگی سریع گوجه فرنگی، سیب زمینی و خیلی از محصولات مهم دیگر شوند.
یک عامل بیماری زای مرموز و صبور
این مطالعه که در مجموعه مقالات آکادمی ملی علوم آمریکا/ PNAS پخش شده، حاصل همکاری محققان صدمه شناسی گیاهی و مهندسی در دانشگاه کالیفرنیا، دیویس است. گونه ای خاص به نام رالستونیا سولاناسه آروم (Ralstonia solanacearum) به سبب صبر و تحملش خیلی خطرآفرین است.
این باکتری می تواند سال ها در خاک مرطوب زنده بماند بدون آن که صدمه مشاهده شدنی ایجاد کند؛ اما وقتی بالاخره به یک گیاه نفوذ می کند، به سرعت در رگ های آبی گیاه حرکت می کند. نتیجه این حمله اغلب سریع و چشم گیر است: گیاهان آلوده تنها در عرض چند روز پژمرده می شوند و می میرند.
تیفانی لاو پاور (Tiffany Lowe-Power)، استاد دانشگاه کالیفرنیا، می گوید: تشبیه من این است که آنها سبب حمله قلبی در گیاهان می شوند، برای اینکه رگ ها را مسدود می کنند و سبب پژمردگی و مرگ گیاه می شوند.
یک لایه محافظتی عجیب وغریب
رالستونیا مانند خیلی از باکتری ها، با ترشح یک پوشش محافظ به نام بیوفیلم از خود محافظت می کند. اما رفتار این پوشش با رالستونیا بطورکامل متفاوت می باشد. این ماده به صورت غیرمعمولی شُل و روان است و به باکتری کیفیت لزج و لجنی می دهد. لایه ترشح شده از یک مولکول بلند و شبیه قند به نام اگزوپُلیساکارید ۱ (exopolysaccharide 1) تشکیل شده است.
لاو پاور توضیح می دهد: با روش هایی که متخصصان میکروب شناسی و ژنتیک استفاده می نمایند، توانستیم تا حدی به جواب نزدیک شویم، اما نه به سازوکار اصلی. ما به یک فیزیکدان نیاز داشتیم.
ورود فیزیک به میدان
هَری مَنیکانتان (Hari Manikantan)، استاد مهندسی شیمی که به مطالعه سیالات پیچیده علاقه دارد، وارد این تحقیق شد. او می گوید: من عاشق مطالعه موادی هستم که رفتارهای پیچیده و جالب دارند؛ موادی مانند بزاق، کف، مواد فعال سطحی ریه و حتی اشک. این مواد به ظاهر ساده، از قوانین فیزیکی شگفت انگیزی پیروی می کنند.
مانیکانتان توضیح می دهد: برخی مواد بسته به این که چقدر سریع به آنها نیرو وارد کنید، رفتار متفاوتی دارند. ممکنست در مقابل یک ضربه ناگهانی مثل جامد سفت واکنش نشان دهند، اما با گذشت زمان مثل یک مایع غلیظ جریان یابند.
کشفی که پاسخ داد
با استفاده از تجهیزات آزمایشگاهی، محققان توانستند اندازه گیری های دقیقی از ترشحات باکتری انجام دهند. آنها کشف کردند که این ماده لجنی به سادگی زیر فشار و جریانی که در رگ های گیاه وجود دارد، جریان می یابد. این امر به باکتری اجازه می دهد به سرعت در سراسر گیاه آلوده پخش شود.
متیو کوپ آرگوئلو (Matthew Cope-Arguello)، دانشجوی تحصیلات تکمیلی، یک آزمایش ساده توسعه داد: اگر باکتری های سازنده بیوفیلم را در یک ظرف کِشت رشد دهید و سپس ظرف را کج کنید، آیا ماده لجن مانند به شکل قطره ای می چکد؟
آنها دریافتند که این خصوصیت منحصر به عوامل بیماری زای گیاهی است.
پیامدهای فراتر از یک رشته
این کشف بین رشته ای نه تنها به مبارزه با یک بیماری مخرب کشاورزی کمک می نماید، بلکه پنجره ای جدید به سمت درک رفتار مواد پیچیده در طبیعت باز می کند. مانیکانتان می گوید: حال می توانیم آغاز به مدلسازی ریاضی این پدیده نماییم. این کشف هیجان انگیزی برای دنیای فیزیک ماده نرم است.
این پژوهش نشان میدهد که چه طور همکاری میان رشته های مختلف علمی می تواند به حل مسایل پیچیده کمک نماید و به درک ما از جهان طبیعی عمق بخشد.
۵۸۵۸
منبع: كادایف
این مطلب را می پسندید؟
(1)
(0)
تازه ترین مطالب مرتبط
نظرات بینندگان در مورد این مطلب